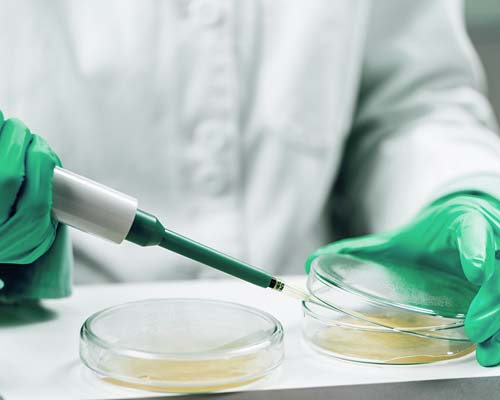
Analiza alimentelor

Laboratoare care oferă întotdeauna ceva în plus
AGROLAB, more than analysis

AGROLAB GROUP este un grup de laboratoare activ la nivel european, cu aproximativ 2.600 de angajați în peste 30 de locații. Oferim servicii de analiză pentru domeniile agricol, de mediu, apă, alimente, furaje și produse petroliere. În aceste domenii ne numărăm printre liderii europeni în ceea ce privește raportul calitate-preț. Clienții apreciază analizele noastre fiabile și rapide, precum și serviciile noastre excelente.
Pentru toate analizele privind calitatea și siguranța alimentelor, AGROLAB este partenerul potrivit. Tehnologia de laborator de ultimă generație, metodele analitice validate și personalul cu experiență garantează rezultate fiabile și rapide.